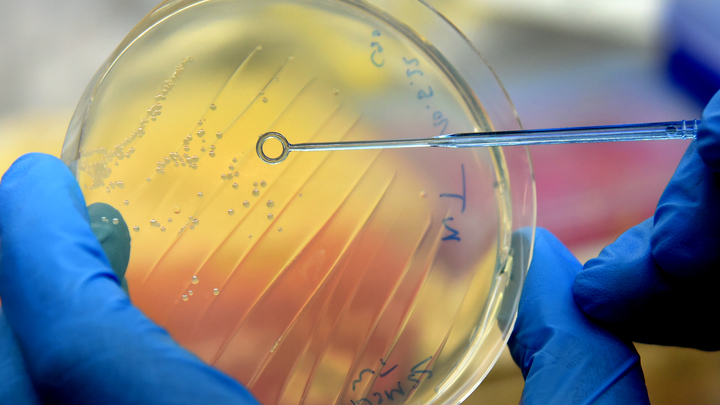
Армения отказала США: Неожиданный поворот в разработке биологического оружия

Армения отказала США: Неожиданный поворот в разработке биологического оружия
Армения намерена отказаться от выполнения обязательств передавать Минобороны США образцы опасных патогенов. Соответствующие изменения внесены в армяно-американский договор в сфере биологической деятельности.
На заседании кабмина в четверг было принято решение внести изменения в соглашение "О сотрудничестве в области предотвращения распространения технологий, патогенов и знаний, которые могут быть использованы в ходе разработки биологического оружия". Оно было подписано в 2010 году между МЧС Армении и Министерством обороны США.
Теперь Армения не будет передавать США образцы биологических патогенов, передаёт Sputnik Армения.
Отмечается, что поправки внесены в целях обеспечения сбалансированной политики государств в сфере биологической безопасности.